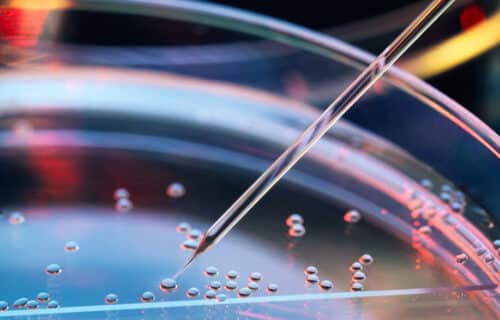

How Silicon Valley hatched a plan to turn blood into human eggs
나이·성별 상관없이 누구나 애 가질 수 있는 시대 열리나…인공 난자 개발에 뛰어든 실리콘밸리
줄기세포를 이용해 인간의 다른 세포들을 생식 세포로 변환하는 기술을 연구하는 스타트업들이 있다. 이들은 우선 인공 난자를 만들어서 임신에 관한 우리의 상식을 모두 깨뜨리고자 한다. 인공 난자를 만드는 것이 어떤 기술인지, 윤리적 문제는 없는지, 현재 진행 상황이 어떤지 알아봤다.